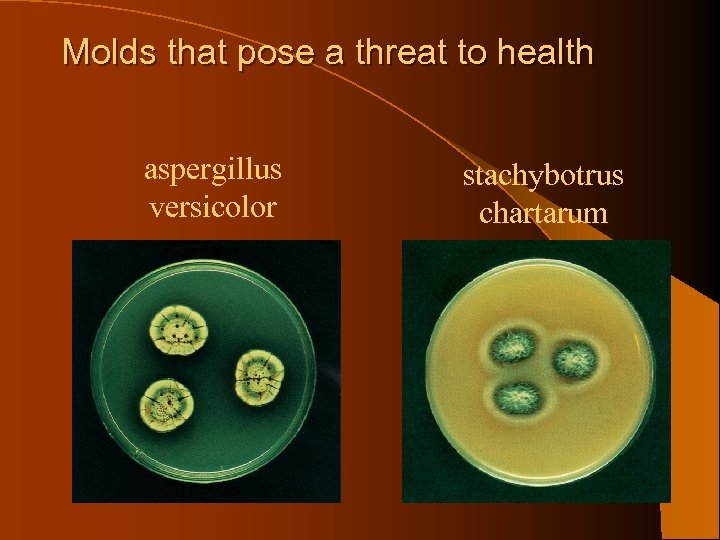
Molds that pose a threat to health aspergillus versicolor stachybotrus chartarum

9196f3052ce1bab67e53860c37636de5.ppt
- Количество слайдов: 55

Mold

Mold—a growing problem

Introduction l Mold Litigation is increasing l Mold Litigation is expensive l Contractors are target defendants

Mold Problems In Buildings Are Not New l Leviticus, Chapter 14, verses 34 – 47 in the Old Testament of The Bible describes mold removal in a house—using methods similar to those used today.

Leviticus, Chapter 14 The LORD said to Moses and Aaron, 34. “When you enter the land of Canaan, which I am giving you as your possession, and I put a spreading mildew in a house in that land, 35. the owner of the house must go and tell the priest, ‘I have seen something that looks like mildew in my house. ’

Leviticus, Chapter 14, cont’d. l 36 The priest shall then command that they empty the house before the priest comes to look at the mark, so that everything in the house need not become unclean; and afterward, the priest shall go in to look at the house.

Leviticus, Chapter 14, cont’d. l 37 So he shall look at the mark and if the mark on the walls of the house has greenish or reddish depressions and appears deeper than the surface l 38 The priest shall return on the seventh day and make an inspection. If the mark has indeed spread in the walls of the house

Leviticus, Chapter 14, cont’d. 38 The priest shall go out the doorway of the house and close it up for seven days. . 39 On the seventh day the priest shall return to inspect the house. 40 If the mildew has spread on the walls, he is to order that the contaminated stones be torn out and thrown into an unclean place outside the town.

First Slide Here

Leviticus, Chapter 14, cont’d. 41 He must have all the inside walls of the house scraped and the material that is scraped off dumped into an unclean place outside the town. 42 Then they are to take other stones to replace these and take new clay and plaster the house.


Leviticus, Chapter 14, cont’d. 43 If the mildew reappears in the house after the stones have been torn out and the house scraped and plastered, 44 The priest is to go and examine it and, if the mildew has spread in the house, it is a destructive mildew; the house is unclean.


Leviticus, Chapter 14, cont’d. It must be torn down--its stones, timbers and all the plaster--and taken out of the town to an unclean place. 46 Moreover, whoever goes into the house during the time that he has quarantined it, becomes unclean until evening. 45

Leviticus, Chapter 14, cont’d. 47 Likewise, whoever lies down in the house shall wash his clothes and whoever eats in the house shall wash his clothes.

Where Does Mold Come From? l Mold is everywhere—indoors and outdoors l There are thousands of mold species l Mold will grow wherever there is moisture, moderate temperature and a food source

What Mold Needs to Grow Food Source (Food is present everywhere, even in the air) Temperature 40 - 100 degrees (The human comfort zone is in this temperature range) Moisture present as water or relative humidity above 60 % (This is the only controllable mold growth component)


If Mold Is Everywhere, What’s The Problem? l No federal or state standards for acceptable mold levels in buildings or homes l Mold levels should be similar indoors and outdoors l Same types of molds should be found indoors & outdoors

What is Mold Exposure? l When moldy materials are damaged or disturbed, mold spores & products are released into the air. l Some molds produce toxic chemicals called mycotoxins that may contaminate air in areas with no visible mold. l People may inhale spores or spores may contact their skin

Does All Mold Exposure Make You Sick? l Not all people exposed to mold will have health problems l Health effects depend on types of mold, amounts of mold and susceptibility of the individual.

Mold-related Health Effects Allergic bronchopulmonary mycosis (ABPM) Allergic bronchopulmonary aspergillosis (ABPA) Allergy Infection Asthma Inhalation fever Bronchitis Legionnaires’ disease Infectious disease Influenza Building-related illness (BRI) Opportunistic fungal infection

Health Effects, Cont’d. Building-related symptom Common cold Organic dust toxic syndrome (ODTS) Pneumonia Conjunctivitis Pontiac fever Crytococcosis Primary amebic meningoencephalitis (PAM) Rhinitis (coryza) Dermatitis Granulmatous amebic encephalitis (GAF) Sick building syndrome

Health Effects, cont’d. Hantavirus pulmonary syndrome (HPS) Histoplasmosis Humidifier fever Sinusitis Hypersensitivity disease (allergy) Tuberculosis (TB) Hypersensitivity pneumonitis (HP) (extrinsic allergic alveolitis) Sore throat Toxic effect

Missing (Health) Links l It is undisputed that certain molds are harmful to human health. l No clear dose-response data to assess potential for health hazard. l No baseline environmental norms established. l The battle rages on. .

Water Intrusion Sources l Building Envelope Leaks l Plumbing Leaks l HVAC condensation/leaks l Wet Building Components l Flooding

Avoiding Mold Growth l Do not install wet or water-damaged building materials l Control humidity when installing finish materials l If a leak occurs, deal with it immediately

Water Damage—Cleanup & Mold Prevention l Within 24 -48 hours of clean water damage l Discard damaged materials – Books & papers (copy if valuable) – Ceiling tiles – Cellulose insulation – Fiberglass insulation – Drywall & gypsum board

Water Damage—Cleanup & Mold Prevention l Use water extraction vacuum, dehumidifier & fans to remove water & reduce humidity from upholstered furniture, carpet, backing, concrete & cinder block surfaces l Wipe all non-porous, hard surfaces with water & mild detergent l Remove water from wood surfaces—use fans, dehumidifier & gentle heat to dry

Building Envelope Problems l Improper flashing installation or lack of – Windows – Doors – Roof parapet walls l Missing/clogged weep holes l Lack of coordination between exterior cladding & window/door installation

Building Envelope Problems l Improperly installed roof drains or scuppers l Improperly installed moisture or vapor barrier l Improper installation of exterior cladding 7 resultant cracking l Improperly installed roofing materials

HVAC Problem Areas l Improper test & balance l Negative pressurization l Improperly located air supply intakes l Condensate pan or pipe leaks

Why Control Humidity? l High humidity can support the growth of pathogenic or allergenic organisms. . l Relative humidity in habitable spaces should be maintained between 30% and 60% to minimize mold growth

Hot/Humid Climates l Dehumidify all incoming air l Positive pressure to outside l Vapor retarder on warm side l Permeable interior wall coverings l Drain the rain

Avoiding Mold Problems In Design & Construction IAQ issues should be part of building program and design. l Controlling humidity should be a design criteria for HVAC system. l Building components (e. g. windows, flashing, exterior skin) must be compatible & water resistant.

Design & Construction Criteria For Hot & Humid Climates l Dehumidify all incoming air. l Provide positive pressure to outside. l Use permeable wall coverings on exterior walls. l Drain the rain.

Avoiding Mold Problems In Design & Construction l HVAC system should be tested and balanced at or before time that owner takes occupancy. l Problems noted in test & balance report should be addressed promptly.

Molds Associated With Water Intrusion l Stachybotrys l Aspergillus l Penicillium l Cladasporium l Fusarium
Molds that pose a threat to health aspergillus versicolor stachybotrus chartarum

How To Prevent Mold Growth l Eliminate l Control water sources humidity –maintain below 60%

Mold Removal Methods l ACGIH Standards l United States Environmental Protection Agency –Mold Remediation in Schools and Commercial Buildings (www. epa. gov/iaq) l City of New York Department of Health Revised Guidelines

Mold Removal Methods l Amount of mold & type of mold determine removal method l Worst case—requires workers to wear Tyvek suits, personal respirators l Worst case—mold removal done under asbestos-type methods l Materials disposed of as hazardous waste

Mold Remediation Methods l Goal— l Remove or clean contaminated materials to prevent fungi or dust from leaving work area l Protect health of workers performing abatement l Method depends on amount of contamination

Level I—Small, Isolated Areas l Can be done by regular building maintenance staff with appropriate training l Gloves & eye protection should be used l Respiratory protection recommended l Work area should be unoccupied; containment not required l Contaminated materials removed in sealed plastic bags

Level I—continued l Work areas should be cleaned with damp cloth or mop and detergent solution. l All areas should be left dry & visibly free from contamination & debris. l There are no special requirements for disposal of moldy materials l Use of biocides not recommended.

Level II—Mid-size Isolated Areas l In addition to Level I requirements: l Work area should be covered with plastic sheet (s) & sealed with tape to contain dust/debris l Dust suppression methods recommended prior to remediation l Work area should be HEPA vacuumed

Level III—Large Isolated Area Health & Safety professional with experience in microbial investigations should be consulted for oversight l Personnel should be trained in handling of hazardous material. l Ventilation ducts/grills in work area should be sealed l Level II requirements should be followed l

Level IV—Extensive Contamination l 100 + contiguous square feet of contaminated area l Professional personnel

Mold Cases = Big Dollars l l l Martin County v. Centex-Rooney--$20 million Polk County Courthouse--$40 mllion Ballard case (Texas)--$32 million verdict against homeowners insurance company Hatley case (Arizona)--$4. 2 million verdict against insurance company Anderson case (California) $18. 5 million verdict against insurance company

Designers & Constructors Are Target Defendants l Owners look to designers and constructors to advise them about potential mold problems. l If water intrusion or humidity problems arise, owners look to designers and constructors to solve these problems—or pay the cost to solve them.

Methods To Avoid Liability l Contract waivers or disclaimers l Written recommendations for inspection and for maintenance. l If something doesn’t smell right, don’t ignore it!

Indicators Of A Mold Problem l If you can see it or you can smell it, there is a problem! l Investigate pipe leaks, condensation drips, roof leaks, window leaks. l Investigate discolored areas on wall surfaces, ceilings, etc.

What Should You Do If You Think There Is A Significant Mold Problem? l Detailed visual inspection by a trained professional of: l Basement or crawl spaces l Rooms with water or flood damage l Window frames & carpets l Ceiling tiles

What Should You Do Cont’d. l Any formerly damp material –books, papers, wallpaper, insulation l All HVAC components l Greenhouses or water features l Attics l Other areas with water—pools, kitchens, spas, laundry rooms, bathrooms

9196f3052ce1bab67e53860c37636de5.ppt